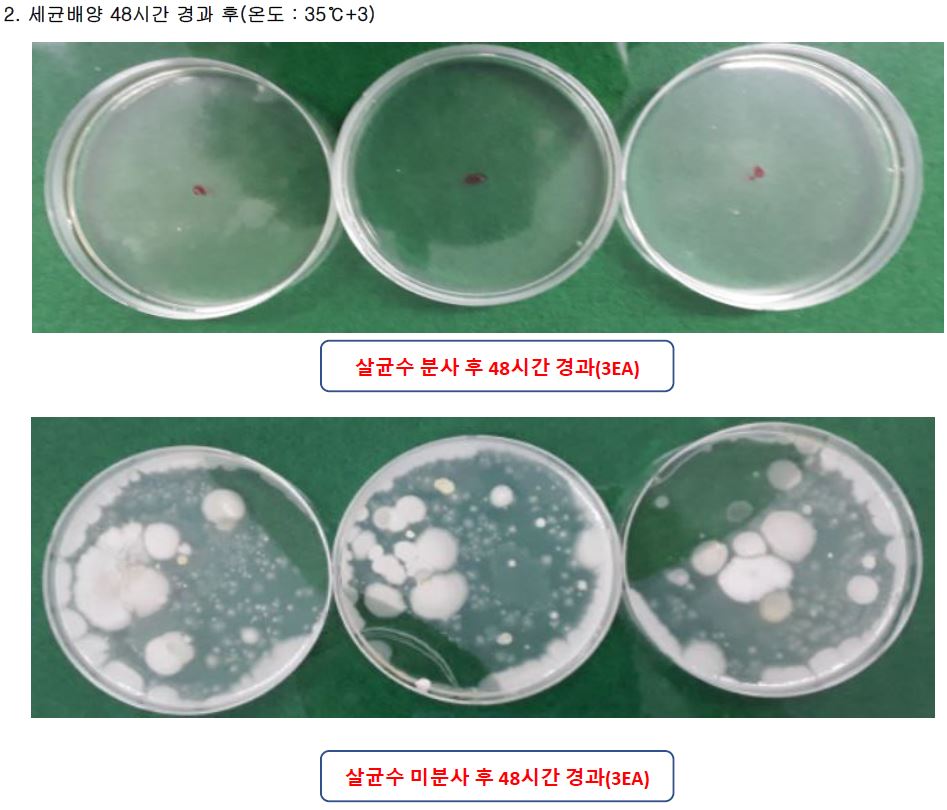

오늘은 차아염소산나트륨 걱정 없는 건강한 전해수기를 소개해드려 볼까 합니다.

본론으로 들어가기 앞서, 차아염소산나트륨이 무엇인지 간단하게 말씀을 드려보도록 하겠습니다.
"차아염소산나트륨이란 소금물을 전기분해하여 생산한 염소제로,
락스의 주 성분이다."
즉, '차아염소산나트륨 = 락스'라고 보시면 됩니다.

보통 화장실 청소를 할 때 위와 같은 락스를 많이 사용하곤 합니다.
왜냐하면,
"락스(차아염소산나트륨)는 소금물을 전기분해하여 얻을 수 있는 염소제이기 때문에 저렴하고,
표백력과 세정력이 뛰어나기 때문입니다."
하지만 락스의 치명적인 단점이 한 가지 있습니다.
모두가 아시겠지만,
"물과 적절히 희석하지 않고 락스(차아염소산나트륨) 원액을 사용하게 되면
인체에 해로울 수 있다는 것입니다."
https://www.news1.kr/articles/?1966450
경기, 급식실 살균소독제 락스 '유해성' 논란(종합)
사실 앞에 겸손한 민영 종합 뉴스통신사 뉴스1
www.news1.kr
이로 인해 작년에는 전해수기의 인체 유해성 논란에 대한 기사가 많이 올라왔었죠.
가뜩이나 코로나 19 바이러스로 시끄러웠던 작년인데,
전해수기가 살균과 관련이 깊은 제품이다 보니 이슈가 많이 됐었던 것 같습니다.
https://www.ibabynews.com/news/articleView.html?idxno=84147
‘락스 물이 몸 속으로’ 가정용 전해수기 안전 논란 - 베이비뉴스
【베이비뉴스 김윤정 기자】“소독제를 분사하는 방법은 흡입할 위험이 있다. 소독액을 천에 적신 후 표면을 닦아줘야 한다.”환경부가 세부지침으로 전한 차아염소산나트륨의 안전한 사용법
www.ibabynews.com
그 이유는 대부분의 가정용 전해수기에서 나오는 액체가 바로 차아염소산나트륨이었기 때문입니다.
즉, 물과 소금 성분을 전해수기에 넣고 작동시키면 그 물과 소금 성분이 전기 분해되어 차아염소산나트륨이 생성됐던 것이죠.
락스의 주요 성분인 차아염소산나트륨을 뿌리면 세정은 잘 되겠으나..
인체에 유해할 수 있다는 것이 문제였습니다.
하지만 제가 오늘 소개해드릴 전해수기는 이와 같은 락스의 주된 성분인 차아염소산나트륨 문제로부터 자유롭습니다.

제가 오늘 소개해드릴 전해수기인 사나래 워터케어 전해수기입니다.
이 전해수기는 소금물을 전기 분해하지 않고 수돗물 그 자체를 전기 분해하는 방식으로 살균수를 생성합니다.
그 과정을 간략하게 말씀드리면 다음과 같습니다.

싱크대에 이 전해수기를 설치하고 수돗물을 틀면,
수돗물이 전해수기 안쪽에 있는 전기분해 카트리지와 만나서 전기 분해됩니다.
이렇게 전기 분해된 수돗물은 차아염소산수로 바뀌게 되는데,
이 차아염소산수가 바로 살균수라고 보시면 됩니다.
차아염소산나트륨과 차아염소산수는 서로 다른 성분입니다.
소금물을 전기 분해하여 만들어진 성분이 차아염소산나트륨이고,
수돗물 자체를 전기분해하여 만들어진 성분이 차아염소산수입니다.
수돗물에는 소량의 염소성분이 포함되어 있어 수돗물을 전기 분해하면 차아염소산나트륨보다 PH농도가 낮고 인체에 무해한 차아염소산수가 만들어진다고 합니다.

이렇게 전해수기를 거쳐 만들어진 차아염소산수는 락스가 가지고 있는 세정력과 표백력이 없지만,
살균력은 락스(차아염소산나트륨)보다 뛰어나다고 합니다.
며칠 전에 이 전해수기를 만드는 기업에 직접 방문하여 살균에 관련된 내용을 들었는데,
실제로 전해수기를 이용해 뽑은 살균수로 황색포도상구균 등과 같은 세균을 살균한 자료를 볼 수 있었습니다.

솔직히 말씀드리면 "이게 과연 살균에 얼마나 효과가 있을까?" 하는 의문도 조금 들었는데,
직접 기업 방문을 해서 관련된 내용을 들으니 신뢰가 가더군요.


기업방문을 마친 뒤,
해당 전해수기 샘플을 받고 곧바로 집으로 가서 설치를 해봤습니다.

뭔가 부품이 이것저것 많은 것 같지만,
설치는 생각보다 간단합니다.
싱크대에 연결되어 있는 샤워기 호스를 떼어내고 위에 있는 부품들과 결합해주면 끝입니다.

이런 식으로 말이죠.
이 전해수기는 절수 기능도 포함되어있습니다.

왼쪽 검은색 발판을 밟으면 물을 틀거나 끌 수 있고,
오른쪽 하늘색 발판을 밟으면 살균수를 뽑을 수 있습니다.

검은색 발판을 밞은 모습입니다.
가운데에 빨간불과 파란불이 들어오면서 물이 나옵니다.
절수기를 사용하여 설거지를 하는 영상입니다.
덕분에 발로 편하게 설거지를 할 수 있게 됐습니다.

전해수기의 오른쪽 파란색 버튼을 누르면 살균수가 추출됩니다.
이렇게 살균수를 추출해서 과일이나 채소를 씻어주면 됩니다.

이 살균수를 분무기 용기에 담아 청소를 하는데 써주셔도 됩니다.


이런 식으로 자주 사용하는 변기에 뿌려주시면 됩니다.
물론 락스(차아염소산나트륨)가 가지고 있는 세정 및 표백력은 기대할 수 없겠으나,
그만큼 인체에 영향이 없는 살균수(차아염소산수)이기 때문에 안심하고 사용할 수 있을 것 같습니다.
지금까지 차아염소산수 걱정 없는 전해수기에 대해 말씀드려봤습니다.
코로나 19로 소독과 살균에 대한 관심이 높아진 요즘,
이와 같은 살균수를 생성할 수 있는 전해수기를 하나 장만해 놓는 것도 나쁘지 않다는 생각이 듭니다.

참 코로나가 세상을 많이 바꿔놓은 것 같다는 생각이 듭니다.
정수기 없는 집을 찾아보기 힘들듯이,
이제 살균수 전해수기 없는 집을 찾아보기 힘든 날이 올까 두렵습니다.
어서 빨리 코로나가 종식되는 날이 왔으면 좋겠습니다..

이번 포스팅에서 소개해드린 전해수기에 대한 세부적인 사항이 궁금하신 분들은
성원 STC 홈페이지나 사나래 서비스센터(1670-3043)에 문의를 해주시면 됩니다😄
지금까지 차아염소산나트륨 걱정 없는 전해수기 포스팅이었습니다.

감사합니다:)
'일상 아이템 리뷰' 카테고리의 다른 글
| 한국포장전 관람 후기(Feat. 스킨포장기) (0) | 2021.10.22 |
|---|---|
| 집에서 떡볶이 만들기(Feat. 떡볶이 소스 추천) (4) | 2021.10.16 |
| 친구 출산 선물 추천 : 스마트하게 건강관리하자! (0) | 2021.10.08 |
| 화장품 OEM 제조사 방문 후기(Feat. OEM 뜻) (0) | 2021.10.06 |
| 1인용 가성비 텐트 추천(실제 사용 후기) (0) | 2021.09.20 |